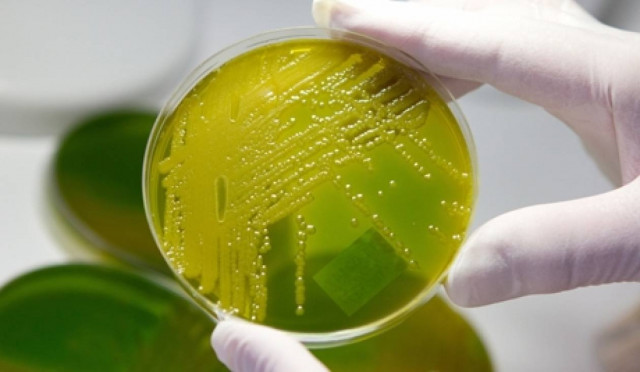
Τα βακτήρια δημιουργούν ηλεκτρικά καλώδια στο βυθό του ωκεανού

ΗΛΕΚΤΡΙΚΑ ΚΑΛΩΔΙΑ

Καθαρά Δευτέρα: Μεγάλη προσοχή στο πέταγμα του χαρταετού – Συμβουλές από τον ΔΕΔΔΗΕ
ΕΛΛΑΔΑ
·
23.02.2026 - 07:58
Ο ΔΕΔΔΗΕ συμβουλεύει τους πολίτες να μην επιχειρήσουν να πετάξουν τον χαρταετό τους κοντά σε ηλεκτροφόρα καλώδια

Καθαρά Δευτέρα: Μεγάλη προσοχή στο πέταγμα του χαρταετού - Συμβουλές από τον ΔΕΔΔΗΕ
ΕΛΛΑΔΑ
·
03.03.2025 - 02:38
Ο ΔΕΔΔΗΕ συμβουλεύει τους πολίτες να μην επιχειρήσουν να πετάξουν τον χαρταετό τους κοντά σε ηλεκτροφόρα καλώδια

Γιατί πρέπει να αποφεύγετε τις προεκτάσεις των καλωδίων φόρτισης
ΑΥΤΟΚΙΝΗΤΟ
·
25.09.2024 - 07:54
Γενικότερα οι προεκτάσεις των καλωδίων φόρτισης δεν είναι και τόσο καλή ιδέα αφού μπορούν να οδηγήσουν από απλές δυσλειτουργίες μέχρι και σε υπερθέρμανση.

Καθαρά Δευτέρα: Συμβουλές από τον ΔΕΔΔΗΕ για το πέταγμα του χαρταετού
ΕΛΛΑΔΑ
·
18.03.2024 - 04:08
Ο Διαχειριστής Ελληνικού Δικτύου Διανομής Ηλεκτρικής Ενέργειας (ΔΕΔΔΗΕ) συμβουλεύει τους πολίτες να μην επιχειρήσουν να πετάξουν τον χαρταετό τους κοντά σε ηλεκτροφόρα καλώδια

Καθαρά Δευτέρα: Προσοχή στο πέταγμα του χαρταετού - Συμβουλές από τον ΔΕΔΔΗΕ
ΕΛΛΑΔΑ
·
15.03.2024 - 04:30
Ο ΔΕΔΔΗΕ συμβουλεύει τους πολίτες να μην επιχειρήσουν να πετάξουν τον χαρταετό τους κοντά σε ηλεκτροφόρα καλώδια

Τραγωδία στη Γεωργία: Τρεις νεκροί σε δυστύχημα με αερόστατο
ΕΛΛΑΔΑ
·
07.02.2024 - 20:06
Το αερόστατο είχε απογειωθεί από το Πότι με προορισμό τον εθνικό δρυμό Βασλοβάνι, στο πλαίσιο προετοιμασίας για την κατάρριψη ρεκόρ Γκίνες
Τα βακτήρια δημιουργούν ηλεκτρικά καλώδια στο βυθό του ωκεανού
ΚΟΣΜΟΣ
·
30.10.2012 - 22:17
Οι βιολόγοι εντόπισαν βακτήρια μεγάλων βαθών, που σχηματίζουν για να επιβιώσουν κάτι παρόμοιο με ζωντανά ηλεκτρικά καλώδια.






